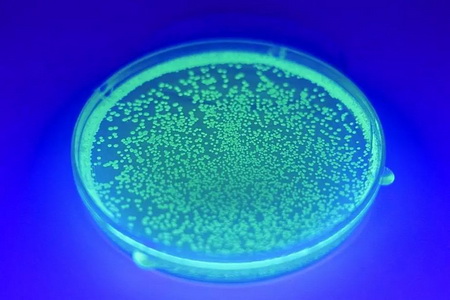

主讲人:Julie Legault Justin Pahara
时 间:2018年3月19日(周一)晚18:00-21:00
地 点:中国美术学院南山校区4-305
主持人:姚大钧
加拿大生物艺术家、MITMedia Lab研究员JulieLegault及剑桥生物学博士JustinPahara将于3月19日携带生物艺术模块设备“Amino”来到跨媒体学院,以工作坊形式向参与者介绍基因工程和基因编辑技术,讨论基因编辑技术的科学原理、应用和伦理等话题,并在工作坊现场使用Amino进行生物艺术创作的实践。这是跨媒体艺术前沿工作坊的首期课程,本次工作坊将启动跨媒体艺术学院在媒体艺术前沿多方向的一系列国际创作坊及课程。
生物艺术模块设备Amino系列,是Amino公司研发的基因编辑套件,它能够支持基因生物学的初学者使用套件,以安全无毒的试剂和模块化的简易流程,轻松尝试基因编辑及生物艺术。

▲生物艺术模块设备Amino
▲Amino套件支持下制作的插入荧光水母DNA的细菌群落
主讲人简介
Julie Legault,出生于加拿大蒙特利尔,拥有MIT MediaLab科学硕士及英国皇家艺术学院艺术硕士学位,曾任职于伯明翰艺术与设计学院、英国皇家艺术学院以及麻省理工学院。她曾与MIT计算机科学教授KevinSlavin下属的Playful System研究小组合作开发移动程序“20 Day Stranger”、艺术装置“Homeostasis”、可穿戴声音装置“radiO_o”等科技艺术作品。现为AminoLabs创始人、CEO及创意总监。

▲JulieLegault
JustinPahara,剑桥大学生物技术和生物电子学博士,曾工作于生命科学领域。截至目前已在“生物黑客空间(biohackerspace)”、高校及企业举办过逾100场生物工程讲座及工作坊。现为AminoLabsCSO。

▲JustinPahara
Julie Legault个人网站:http://julielegault.com/
AMINO LABS网站:https://amino.bio/

